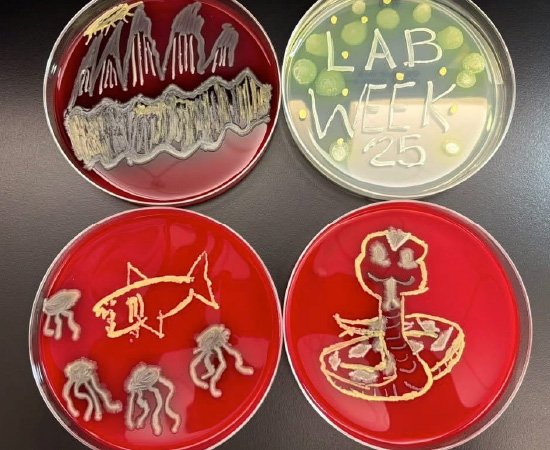
2025 Volunteers Appreciation Week Contest Winners - 1st Place

CONTEST CENTRAL
Congratulations to the winners! Take a look at what these amazing customers achieved!
Did you recently hold an unforgettable appreciation or awareness event? Tell us about it for a chance to win special prizes in our Positive Contests!

We Want To Hear About Your
Nurses and Nursing Assistants Week Celebrations!
CAPTURE THE CARE – SHOW US YOUR STORIES!

Grand Prize $300

Second Prize $200

Third Prize $100
ENTRY DEADLINE TO BE ANNOUNCED...
2025 Nurses & Nursing Assistants Contest Winners
Congratulations to the winners of this year’s Nurses & Nursing Assistants contest!
Grand Prize Winner - 1st Place
Yuma Rehab Hospital - Yuma, AZ


YRH celebrated Nurses Week with a focus on Rest, Relaxation, and Mindfulness for nurses and rehab techs. The main gift, a mini massage gun from Positive Promotions, supported the relaxation theme. Daily giveaways included self-care items like shower steamers, hand masks, and face masks, along with food and activities. Staff were encouraged to visit a Relaxation & Selfie Station and complete a Blissful Station Passport for raffle entries, with prizes for both day and night shifts. An additional raffle entry was offered for attending a special wellness talk by nurse and motivational speaker Deb Bershad, who spoke about maintaining personal well-being while caring for patients.
2nd Place Winner
VA Medical Center - White River Junction, VT



At the WRJ VA Medical Center, the Nursing Workforce Council organized a creative and activity-filled Nurses Week despite having no official budget, funding all events through staff donations. The week featured a variety of engaging activities such as a Ping-Pong tournament, Cookie Bake-Off, Ice Cream Sundae Bar, mini massages, photo booth, virtual Bingo, and an awards ceremony. Departments also participated in the 3rd Annual Wreath Decorating Contest and enjoyed themed days like “Aloha Friday.” Additional highlights included guest speakers, educational presentations, and special treats delivered via a coffee cart for both day and night shifts. Lunch bags from Positive Promotions were used as raffle prizes, helping make the celebration fun, meaningful, and inclusive for all nursing staff.
3rd Place Winner
DC Child and Family Services Agency - Washington, DC



Throughout May, the agency celebrated Nurses Month with weekly themed events highlighting appreciation, wellness, and community service. The celebration began on May 7 with a kickoff event and guest speaker on “The Power of Nurses,” attended by nurses, students, and nursing leaders. The day included a Nurse of the Year award, a catered lunch, and a photographer to capture the occasion. Later weeks featured a wellness day with yoga, massages, and relaxation rooms; an appreciation lunch and service project where nurses packed 150 toiletry bags for shelters and patients; and concluded with a CPR renewal class and ice cream social. A dedicated volunteer committee began planning in February to ensure a meaningful month-long celebration, which received enthusiastic feedback from attendees and guests.
Honorable Mentions
AdventHealth Hospital - Winter Springs, FL
California Department of Corrections - Visalia, CA

Earn A Prize For Your School!
Tell Us About The Special Ways You Celebrated
PRIZES WILL BE AWARDED TO THE TOP 3 ENTRIES!

Grand Prize
$300

Second Prize
$200

Third Prize
$100
HURRY! ALL ENTRIES MUST BE RECEIVED BY JUNE 5, 2026
2025 Teacher & Staff Appreciation Week Contest Winners
Grand Prize Winner - 1st Place
Gardner Education Center - Longhorne, PA


The team at Gardner Education Center knocked it out of the park all week long with appreciation gifts and baseball-themed activities! From baseball bingo and trivia to traditional ballgame treats like hot dogs, pretzels, cotton candy, and Cracker Jacks®, everyone got a chance to join the big leagues. Plus, they enjoyed great prizes like 40-oz. Tumbler Bags, Can Coolers, and even tickets to a Philadelphia Phillies game. Not a single strike in the celebration! "I am honored to work with such a hard-working, caring group of people who serve an entirely special education population." —Suzie Zabicki, Principal
2nd Place
Edison Elementary - Bristow, OK 74010


The folks over at Edison Elementary hosted a week-long Wild West fandango chock-full of activities and lots of good eats fit to satisfy any hankering. The buckaroo blowout featured bites like hearty breakfast casserole, a make-your-own trail mix chuck wagon, a sweet and refreshing watering hole, and a good ol' campsite BBQ. To top off the kit and caboodle, teachers received gifts from our exclusive Raffle/Value Packs. A rootin' tootin' good time was had by all! "Thank you so much for helping us pick out prizes and getting them to us so quick to make our Teacher Appreciation Week enjoyable for all of the employees."—Tammy Shelton, Principal
3rd Place
CADA Head Start/Early Head Start Centers - Enfield, NC 27823


Hitting the runway with a Flight Around the World theme, teachers and staff at CADA Head Start/Early Head Start Centers were treated with one-way tickets to the lands of appreciation and fellowship! Festivities took off with kindness grams shared between the cabin crew. All week long, everyone could fuel up with breakfasts and snacks galore. The celebration had a great landing with Positive Promotions cargo on board, including our popular Lunch/Cooler Bags! "The week fostered gratitude, connection, and joy among all staff members."—Regina Lewis, Family Service Specialist
Honorable Mention
NYISE Readiness Program - Bronx, NY 10469
The NYISE celebrated Teacher Appreciation Week by honoring its dedicated teachers and teaching assistants for their patience, creativity, and impact on students' growth and success—highlighting their hard work, positivity, and commitment with heartfelt messages of gratitude and recognition shared throughout the week. Staff were publicly acknowledged and celebrated for making a lasting difference in their students' lives.

Earn A Cash Prize For Your Facility
Tell Us About Your Medical Laboratory Professionals Week Activities
SEND US YOUR PHOTOS • SHARE YOUR IDEAS • ENTER TODAY!

Grand Prize
$300

Second Place Prize
$200

Third Place Prize
$100
HURRY! ALL ENTRIES MUST BE RECEIVED BY JUNE 1, 2026
2025 Med Lab Professionals Contest Winners
Congratulations to the winners of this year’s Nurses & Nursing Assistants contest!
Grand Prize Winner - 1st Place
Pierpont Community & Technical College - Fairmont, WV

Pierpont Community & Technical College’s Medical Laboratory Technology program celebrated Medical Laboratory Professionals Week 2025 with a mix of educational, creative, and stress-relieving activities for students and faculty. Highlights included crossword and word search games, a Microbe Art contest, and a “Lunch and Learn” session on molecular diagnostics aboard the International Space Station. Participants received lab-themed gifts from Positive Promotions, and each student got a Lab Week gift bag. The program also introduced a mascot named “Duffy”, honoring a red blood cell antigen, and organized field trips to Quest Diagnostics and Vitalant Blood Center, combining learning, collaboration, and celebration of the laboratory profession.
2nd Place Winner
Mercy Medical Center - Baltimore, MD


The Lab Week celebration featured a full schedule of educational sessions, themed activities, and staff appreciation events. Festivities began with two Lunch & Learn sessions and a Pathologist-sponsored breakfast and dinner, followed by decorations, photo ops, and spirit days. Throughout the week, staff enjoyed multiple Breakfast & Learn and Lunch & Learn presentations, a Lab Open House, and a popular ice cream social. Games included puzzles, scavenger hunts, Bingo, and a Lab Mascot contest, keeping everyone engaged. Each employee received a Positive Promotions backpack and candy bar, with raffle prizes— including a 50” TV—adding excitement to a week filled with fun, learning, and teamwork.
3rd Place Winner
Newton-Wellesley Hospital - Newton, MA



Newton-Wellesley Hospital celebrated Lab Week with a full week of themed dress-up days, games, and team activities. Highlights included crazy accessories, silly hats, favorite sports team, and tie-dye days, along with an ice cream social, breakfast, and pizza day. A photo booth and “Mystery Machine” display added fun and visibility for lab staff, whose photos were showcased to patients. Daily games such as Bingo, Scooby-Doo trivia, Scavenger Hunt, Family Feud, Close-Up guessing, and a Lab Mascot contest kept participation lively. Winners received Positive Promotions prizes, which were a big hit among staff.
2026 Mother's Day Celebration Contest
3 JUDGED CATEGORIES • 3 CASH PRIZES!
$300 Prize for Best Use of Products, $200 Prize for Most Creative, and a $100 Prize for Most Inspiring
BEST USE OF PRODUCTS

Grand Prize
$300
MOST CREATIVE

Second Place Prize
$200
MOST INSPIRING

Third Place Prize
$100
How do YOU celebrate? Send in a typed description of the joyful ways you express appreciation to the wonderful mothers of faith in your congregation

We Want To Hear About Your
National Volunteer Week Activities
WE WILL AWARD THE THREE BEST AND MOST CREATIVE ENTRIES!

Grand Prize $300

Second Prize $200

Third Prize $100
HURRY! ALL ENTRIES MUST BE RECEIVED BY JUNE 1, 2026
2025 Volunteers Appreciation Week Contest Winners
Congratulations to the winners of this year’s Volunteer Week contest!
Grand Prize Winner - 1st Place
West Viriginia University Hospitals - Morgantown, WV



To kick things off, WVU Hospitals Volunteer Services emailed volunteers a thank-you letter from their president & CEO along with an event flyer to generate excitement. They used posters, banners, balloons, and handmade decorations to encourage hospital-wide participation. On top of the abundant thanks, both on- and off-site volunteers were given snack bags—some of which contained a scratch-off ticket to win a gift from the Positive Promotions Scratch & Win Prize Pack—and pens. Great job, WVU Hospitals!
2nd Place Winner
Grace Lutheran - Greensburg, IN



Grace Lutheran Community provides housing for those who are 62+ and/or mobility impaired. Their resident volunteers help with maintenance like cleaning and gardening while outside volunteers plan several activities a month to keep residents active. Volunteers were honored with a party consisting of pizza, cupcakes, and zippered tote bags from Positive Promotions to help them easily carry groceries, library books, and more. Thanks for sharing!
3rd Place Winner
Arrowhead Lodge Senior Living - Rapid City, SD

Arrowhead Lodge Senior Living celebrated their volunteers' service with a private lunch and plenty of volunteer-themed gifts. Each volunteer was given a soup mug gift set and raffle entry to win a water bottle filled with bite-sized chocolates, a lapel pin, and a flashlight, all from Positive Promotions. A great event was had by all!

Earn A Cash Prize For Your School Or Organization
Tell Us About Your Black History Month Activities
WE WILL AWARD THE THREE BEST AND MOST CREATIVE ENTRIES!

Grand Prize $300

Second Prize $200

Third Prize $100
HURRY! ALL ENTRIES MUST BE RECEIVED BY APRIL 11, 2026
2025 Black History Month Contest Winners
Congratulations to all the winners of the Black History Month 2025 Contest! Your creativity, dedication, and passion for honoring Black history and culture truly shined through your celebrations. Thank you for making this month meaningful, educational, and inspiring for your communities.
Grand Prize Winner - 1st Place
Faith Tabernacle Church - Cleveland, OH

Faith Tabernacle United Holy Church in Cleveland, Ohio celebrated Black History Month 2025 with the theme "Roots of Resilience: Black History Across Generations" (Psalm 145:4). Each Sunday featured a unique focus: we kicked off in Red, Black, and Green and launched a popular Pop-Up Shop with Black History-themed items. The second Sunday was T-Shirt Day, highlighting HBCUs. On the third Sunday, we honored church mothers aged 90+ with flowers and lapel pins. The celebration culminated with youth speeches, Afrocentric attire, and a Heritage Dinner. Thanks to Positive Promotions for inspiring a memorable and meaningful month!



2nd Place Winner
Greater Peace Missionary Baptist Church - Killeen, TX


Greater Peace Missionary Baptist Church in Killeen, TX hosted a successful Black History Prayer Breakfast and Program on February 15, 2025, with over 90 attendees, including guests from local and out-of-town churches. Guests were welcomed by committee members in themed T-shirts reading "Rooted in Faith, Prayer, and God". The Fellowship Hall was vibrantly decorated with Black History visuals, and a delicious breakfast was served. The program featured music, speakers, and a keynote address from Killeen’s first Black female mayor, Ms. Debbie Nash King. The event beautifully honored the past while inspiring hope for the future.


3rd Place Winner
Jackson Middle School - Titusville, FL


Jackson Middle School celebrates Black History Month each year with engaging, school-wide activities that highlight the richness of Black history and culture. With the help of Positive Promotions, we decorate the school, distribute themed materials, and create interactive learning experiences. A central event is our Wing Wars door decorating contest, where teachers and students creatively showcase the yearly theme across different wings. Past themes have included the Civil Rights Movement, Africa Before the Slave Trade, the Harlem Renaissance, African musical influences, and in 2025, The Divine 9. Each theme is further explored through morning news presentations, bulletin boards, and student-led research.






Prizes play a key role in encouraging participation. Students earn incentives like pencils, bracelets, buttons, bookmarks, water bottles, and keychains from Positive Promotions for joining trivia games, scavenger hunts, and other activities. Teachers also receive recognition and gift certificates for best-decorated doors. These rewards help build excitement and reinforce the educational value of the month-long celebration.


WINNERS BLOCK

Congratulations to the Red Ribbon Week Contest Winners!
Thank you for participating and sharing your activities!
Be ready to get gear up for our next one!

2025 Red Ribbon Week Contest Winners
Schools and organizations from coast to coast celebrate Red Ribbon Week in many creative and fun ways each October. Positive Promotions is pleased to help make these events meaningful and recognize those who go above and beyond to let kids know the importance of staying drug free and being kind. Let our 2025 contest winners inspire your 2026 Red Ribbon Week observances.
Grand Prize Winner - 1st Place
Brantley School
Brantley, AL



To kick off Red Ribbon Week, students attended an assembly featuring the Covington Sheriff’s Department, who demonstrated their drug dog and shared the importance of staying drug-free. Throughout the week, students participated in daily dress-up themes, showing school spirit while reinforcing positive decision-making.
Each morning included a trivia question on health, safety, and positive living. Teachers who answered correctly earned a jean pass—sparking a fun, highly competitive game as students eagerly shouted out answers. Students also joined a Halloween-themed coloring contest promoting a drug-free message, with winners receiving swag bags.
Special guests—including a district judge, juvenile probation officer, and career coach—visited classrooms to share stories about making good choices, kindness, and healthy living.
Every student received daily giveaways, including themed stickers, pencils, ribbons, bracelets, and color-changing cups. The week brought the school together to celebrate teamwork, positivity, and the belief that every student plays an important role.
2nd Place
Centre Avenue Elementary School
East Rockaway, NY
Students at Centre Avenue celebrated Red Ribbon Week by decorating puzzle pieces with prompts focused on healthy choices and the people who support them. Each class designed a piece based on a grade-level theme, and support staff assembled them into grade-level puzzles to symbolize how everyone fits together. Teachers and staff also had the option to purchase matching red shirts, worn during Spirit Week to show unity. Throughout the week, students learned the meaning of Red Ribbon Week and how to make positive, healthy choices as part of their pledge.

3rd Place
Warren Central Elementary School
West Lebanon, IN


Red Ribbon Week at Warren Central is a well-planned, school-wide effort focused on more than just fun—its goal is to help students understand the importance of resisting peer pressure, making healthy choices, and identifying trusted adults for support. Each day begins with announcements reinforcing these messages.
For the past four years, the school resource officer and counselor have visited all K–6 classrooms, reaching 375 students with lessons on staying drug-free, making positive decisions, and using healthy coping strategies. Older students also learn about the risks of vaping and drug use, along with ways to support their mental well-being.
The week features themed dress-up days to promote school spirit, including “Swap Out Drugs,” “Books Build Character,” “Red-y, Set, Be Drug Free,” “Headed for Success,” and “Rock Your Socks.” Participation is high, with special prizes awarded to students who go all out—especially on the all-red day.
Students also take part in a Coloring & Poster Contest. Grades K–3 complete drug-free coloring sheets, while grades 4–6 create original posters. Winners are selected by teachers and the principal, with artwork displayed throughout the school.
Every student receives daily incentives, including red ribbons, pencils, and stickers, with additional prizes like bracelets, balls, and cups earned during classroom activities.
Through engaging lessons, interactive activities, and school-wide participation, Warren Central uses Red Ribbon Week to build a strong foundation for lifelong healthy choices—empowering students to stay drug-free and confident in their decisions.
Honorable Mention
Leonard Brautigam Center
Houston, TX
Honorable Mention
Rockbridge Elementary
Stone Mountain, GA

Presenting the Winners from Our Holiday Gifts Celebrations Contest
Thank you for sharing your special celebrations!
Next year can’t come soon enough—bring on more holiday joy!

2025 Holiday Gifts Contest Winners
Congratulations to the winners of our first Holiday Gifts contest! Take a look at the merry moments that make year-end celebration special shared by our amazing customers!
Grand Prize Winner - Most Creative 1st Place
Copper Kitchen - Baltimore, MD
We decided to celebrate the 12 Days of Christmas by giving each employee a stocking. At the end of each day, they receive a small token of appreciation. We took it a step further by tying each gift to one of our eight core values—Communication, Respect, Accountability, Balance, Love, Integrity, Fun, and Excellence—spelling out “CRABLIFE.”
This theme holds special meaning for us here in Maryland, where crabs are truly a way of life. On day three, we gave out your Pure Comfort Socks and connected them to Accountability with a short, clever message about stepping up. They are incredibly warm, cozy, and have quickly become a favorite with everyone.
Thank you for helping us bring our CRABLIFE Christmas to life!

Grand Prize Winner - Best Use Of Products 1st Place
Quest Diagnostics Inc. - Roanoke, VA
Our 2025 team holiday celebration was fun, festive, and full of surprises—thanks to Positive Promotions! With a $15 per-person budget for either a gift or a team meal, we chose to give a gift to ensure each of our hardworking colleagues felt recognized and appreciated.
When it came time to choose, we looked no further than Positive Promotions, knowing we could count on both quality and value. Each team member received a buffalo plaid lunch bag filled with a Hershey’s-filled metal holiday ornament, a Fair Isle stylus metal pen, and a color-changing buffalo plaid ceramic mug with a hot chocolate gift set.
Our team loved the surprise and was impressed by the presentation and variety of items. We’ll continue to turn to Positive Promotions when celebrating and recognizing our employees.

Grand Prize Winner - Most Festive 1st Place
Visiting Angels - Cincinnati, OH



We celebrate the holidays by bringing together the heart of our organization—our caregivers. Because they serve clients in their homes each day, we don’t often have the chance to gather. So on Friday, December 19, we turned payday into a celebration and gift-giving event.
Caregivers were welcomed with food, music, laughter, and the joy of reconnecting. As a thank-you for their dedication and compassion, each received a cozy blanket and “We Put Our Heart and Soul into All We Do” socks along with their paycheck—a small but meaningful symbol of warmth, comfort, and appreciation. The gift bags were even arranged to resemble a Christmas tree. :)
Mike, our owner, personally shared holiday wishes and gifts, reminding everyone how valued they are. For us, celebrating the holidays means creating moments of connection, gratitude, and warmth for those who give so much all year long.
The office staff even put their socks on right away and are already using the blankets to stay warm during chilly winter days.



2nd Place Winner - Most Creative
YES Prep Public Schools - Houston, TX

We celebrated our staff with awards and swag for all their hard work feeding our students this past year. It was great and everyone loved the blankets from Positive Promotions! :)

2nd Place Winner - Most Festive
Alief ISD - Houston, TX




Our department of approximately 400 staff hosts an annual winter celebration before the district closes for break. As the Child Nutrition team at Alief ISD, our group includes kitchen staff from all schools, along with managers, supervisors, and office staff.
This year’s event was especially memorable, with a great turnout and a fun ’70s-themed party planned by our supervisory team. One of the biggest highlights was a gift for each employee from Positive Promotions—personalized charcuterie boards that came with snacks and were individually gift-wrapped.
They were fantastic, affordable, and a huge hit with everyone. Thank you!



2nd Place Winner - Best Use Of Products
Sinclair Lane Elementary School - Baltimore, MD
This year, I wanted to make the holidays truly special for my staff by showing how deeply they are appreciated. As a first-year principal, it was important to create a meaningful gesture that reflected gratitude, care, and recognition for their hard work.
I selected personalized appreciation gifts—including “Thanks for All You Do” winter scene cooler bags, soy candles in holiday gift boxes, and “We Put Heart & Sole Into All We Do” comfort socks—and shared them at our staff holiday party. Each gift was paired with a warm meal and jackets served at dinner, creating a thoughtful and celebratory experience.
For me, this wasn’t just about gifts—it was about honoring the dedication, compassion, and resilience my staff brings every day. It was my way of saying thank you, boosting morale, and beginning my leadership journey by putting people first.

Honorable Mentions
The Samaritan Center - Cleveland , TN
Our staff took time to come together and celebrate a year of hard work, dedication, and commitment. As our community grows, so does our positivity and passion for our center’s mission.
Instead of a traditional Christmas meal, we chose a “Lunch Brunch” theme—something quick and easy so we could focus on spending time together. I celebrated my staff with buffalo plaid lunch boxes, choosing a gift that’s practical for everyday life—after all, we all work, and we all have to eat!
We played games like Dirty Elephant, shared plenty of laughs, and made lasting memories along the way. Thank you for being such an important part of our 2025 Christmas celebration!


Honorable Mentions
City of Manassas DSS - Manassas, VA
We spend a great deal of time with our coworkers, who often become an extended family. Taking time to celebrate the diverse traditions and cultures around us can help ease the stress of the holiday season.
Honorable Mentions
Ebenezer AME Usher Board - Waldorf, MD
We held our holiday celebration on December 7, 2025, featuring a festive meal for approximately 45 ushers as part of our First Sunday gathering.
Each usher received a Mini 2-in-1 Lantern/Flashlight as a gift. They were excited and appreciated its practicality, noting it could be useful in a variety of situations. Overall, the gift was very well received.


Annual Breast Cancer Awareness Contest!
Be ready to get inspire for our next
one!
Thank you for participating!
Be ready to get inspired for our next contest!

2025 Breast Cancer Awareness Contest Winners
Congratulations to the winners of last year’s Breast Cancer Awareness Month contest! Take a look at what these amazing customers achieved in their missions for a better, healthier future.
BEST USE OF PRODUCTS WINNERS
Grand Prize Winner - 1st Place
Gordon County Health Department | Calhoun, GA



In 2025, the health department hosted its first annual breast cancer awareness event and offered participants free breast exams. Participants also received Tote Bags, Water Bottles, and more purchased from Positive Promotions. The health department solicited donations from local businesses to use as door prizes, giving women extra incentive to attend. But the focus on preventive healthcare didn’t stop there. Eligible participants were enrolled in a program that would cover the cost of additional, free health screenings, including an annual exam, mammogram, and Pap smear.
Best Use of Products - 2nd Place
EMCOR Group, Inc. | Norwalk, CT



EMCOR Group has long been a champion of breast cancer awareness and is deeply committed to fighting the disease. Every October, both at the corporate level and through the initiatives of its subsidiaries, EMCOR helps bring attention to this important cause. We have supported the Making Strides of Fairfield County Breast Cancer Walk, benefiting the American Cancer Society’s research, advocacy, and patient support efforts. The items ordered were given away to survivors, walkers, and anyone who stopped by our table to remind women that early detection is key in fighting this horrible disease. Our main message was: “Protect Yourself. Get Screened Today.”
MOST CREATIVE WINNERS
Grand Prize Winner - 1st Place
Pembina County Memorial Hospital | Cavalier, ND


To spread hope to those fighting breast cancer, the hospital’s auxiliary put together a “Travel Bundle” to raffle off that symbolized the journey of strength, courage, and healing breast cancer patients go through. It included pink luggage, a toiletry bag, a travel pillow, and more. Cozy Socks from Positive Promotions were part of the raffle prize. The hospital’s “Journey In Pink” celebration reminded everyone that every act of kindness, no matter how small, helps move us one step closer to ending breast cancer, a representative from the hospital said
Most Creative - 2nd Place
Keller Breast Center | Sheffield, AL




Every year, we celebrate survivors in our community with a free event featuring lunch, vendors, activities, and guest speakers. This year marked our 10th annual celebration, so we chose “Through the Decades” as our theme. Vendors and survivors were encouraged to dress in attire from their favorite decade. We handed out personalized bags from Positive Promotions, each filled with a personal portable blender and recipes for healthy smoothies and shakes!
MOST INSPIRING WINNERS
Grand Prize Winner - 1st Place
Singing River Health System Cancer Center | Ocean Springs, MS

Every year, an oncologist at the cancer center gives a special gift to all breast cancer patients so they can feel supported, not only medically,but emotionally throughout their cancer journey. She offers each one a Bracelet purchased from Positive Promotions, which serves as a tangible, meaningful token to hold onto during a difficult time. These patients are often seen around the community wearing their Bracelets, which symbolize their personal hope and strength, a representative from the hospital said.
Most Inspiring - 2nd Place
SurviveHER | Missouri City, TX




In October, SurviveHER celebrated Breast Cancer Awareness Month with a full slate of educational, wellness, and community events in Houston and New York City. Our activations included the 5th Annual Sur5HER Soirée, Pink Party on the Plaza in Harlem, church outreach, and multiple community-based wellness events centered on early detection, survivorship, and breast health education. We incorporated Positive Promotions Breast Self-Exam Shower Hangers to reinforce the importance of self-exams, early detection, and knowing what is normal for your body. At each event, we walked women through the step-by-step instructions and encouraged them to hang the cards in their showers as a regular reminder to check their breasts and speak up about any changes.

Congratulations to the
Fire Prevention Week Contest Winners!
Thank you for participating and sharing your activities!
Be ready to get gear up for our next one!

2025 Fire Prevention Week Contest Winners
Congratulations to the winners of this year’s Fire Prevention Week contest!
Grand Prize Winner - 1st Place
Casa Volunteer Fire Department - Casa, AR





Fire Prevention Week was a great success for the Casa Volunteer Fire Department, bringing the community together to raise awareness, recruit new members, and support the department. We hosted a membership drive and fundraiser that welcomed residents, families, and local leaders. A dessert auction added a fun, competitive element, with homemade treats that had everyone laughing and bidding. To strengthen community connections, we invited local politicians currently up for reelection to encourage open conversations about the importance of supporting volunteer fire departments and public safety initiatives. The kids were the highlight of the day, each receiving custom-printed fire hats and badges from Positive Promotions, along with goodie bags filled with candy and promotional items. Custom firefighter cutouts were also a big hit, providing families with a fun photo opportunity while promoting fire safety awareness. Overall, the event successfully raised funds and brought the community together to support fire prevention and safety education. Photos of the activities, including the firefighter cutouts and children enjoying their Positive Promotions items, are included with this entry.
2nd Place Winner
VolunteerLEON Fire Department - Tallahassee, FL





Annually Leon hosts the Volunteer Firefighter Fire Truck Round-up. This event recognizes the contributions of volunteer firefighters serving unincorporated communities. Each year, the county presents the Jack Harron Volunteer Firefighter of the Year Award, named after the longtime fire chief who helped start the event. The event features family-friendly activities including games, giveaways, face painting, bounce houses and carnival food.
3rd Place Winner
Springfield Twp Fire Department - Cincinnati, OH





The Springfield Township Fire Department held its annual Open House on Saturday, October 11, 2025. This long-standing community event, which has been a tradition since the 1960s, was held in recognition of Fire Prevention Week. Firefighters, EMTs, and paramedics hosted a variety of firefighting and rescue demonstrations, including live fire and fire extinguisher demonstrations. Families and children enjoyed hands-on activities such as spraying water, trying on firefighter gear, exploring fire trucks and emergency vehicles, and meeting Sparky the Fire Dog. Community partners were on site sharing safety information, and the University of Cincinnati Air Care helicopter made a special appearance, allowing attendees to meet the flight crew and view the aircraft up close. Guests also enjoyed free food and family-friendly activities throughout the day.
Positive Promotions is honored to offer our customers a chance to win prizes each year through our various event contests. From Black History Month and Teacher & Staff Appreciation Week to Volunteer Week and Breast Cancer Awareness Month, we're always updating this contest page with more ways for you to win, as well as to check the winners of past contests.
Entering a contest is just a click away! Send us a description of your event through our easy online entry form, along with how you used Positive Promotions' products to celebrate your team or raise awareness of a cause. You can also attach photos of your activities or creative work—our staff loves to see how we helped our customers recognize, educate, and inspire! Or, download the entry form and mail it in to the address noted on the form.
All of our Positive Contests have deadlines, so be sure to note the dates by which you have to submit your entries in order to qualify for the top prizes. Thank you for entering, and for trusting Positive for your special events!

















